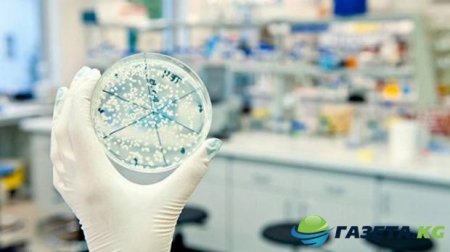

Биологи отыскали «коллективную» форму фотосинтеза бактерий
Биологи Вашингтонского государственного университета в процессе исследований отыскали «коллективную» форму фотосинтеза бактерии. Результаты проведенных наблюдений научные работники опубликовали на страницах издания Nature Communications.
Сообщается, что в процессе работы биологи сумели отыскать несколько видов бактерий под названием Geobacter sulfurreducens и Prosthecochloris aestaurii, которые образуют «коллективную» форму фотосинтеза. По словам специалистов, один микроорганизм, обнаруженный в соленых озерах США, имеет зеленый цвет. Как выяснилось, найденные организмы обычно держатся вместе и используют электроны для фотосинтеза. Вторая бактерия способна перерабатывать в электричество органические отходы, однако не может производить углекислый газ.
В результате исследования биологи выяснили, что бактерия P. аestuarii способна забирать производимые другого микроорганизма электроны во время анаэробного фотосинтеза. Как утверждают ученые, подобные взаимодействия ранее замечены не были, поэтому в процессе «коллективной» работы организмы способны дополнять друг друга. По словам Халука Бейенала, руководителя научной группы, данный биологический процесс в природе может быть достаточно распространенным.
Сообщается, что в процессе работы биологи сумели отыскать несколько видов бактерий под названием Geobacter sulfurreducens и Prosthecochloris aestaurii, которые образуют «коллективную» форму фотосинтеза. По словам специалистов, один микроорганизм, обнаруженный в соленых озерах США, имеет зеленый цвет. Как выяснилось, найденные организмы обычно держатся вместе и используют электроны для фотосинтеза. Вторая бактерия способна перерабатывать в электричество органические отходы, однако не может производить углекислый газ.
В результате исследования биологи выяснили, что бактерия P. аestuarii способна забирать производимые другого микроорганизма электроны во время анаэробного фотосинтеза. Как утверждают ученые, подобные взаимодействия ранее замечены не были, поэтому в процессе «коллективной» работы организмы способны дополнять друг друга. По словам Халука Бейенала, руководителя научной группы, данный биологический процесс в природе может быть достаточно распространенным.